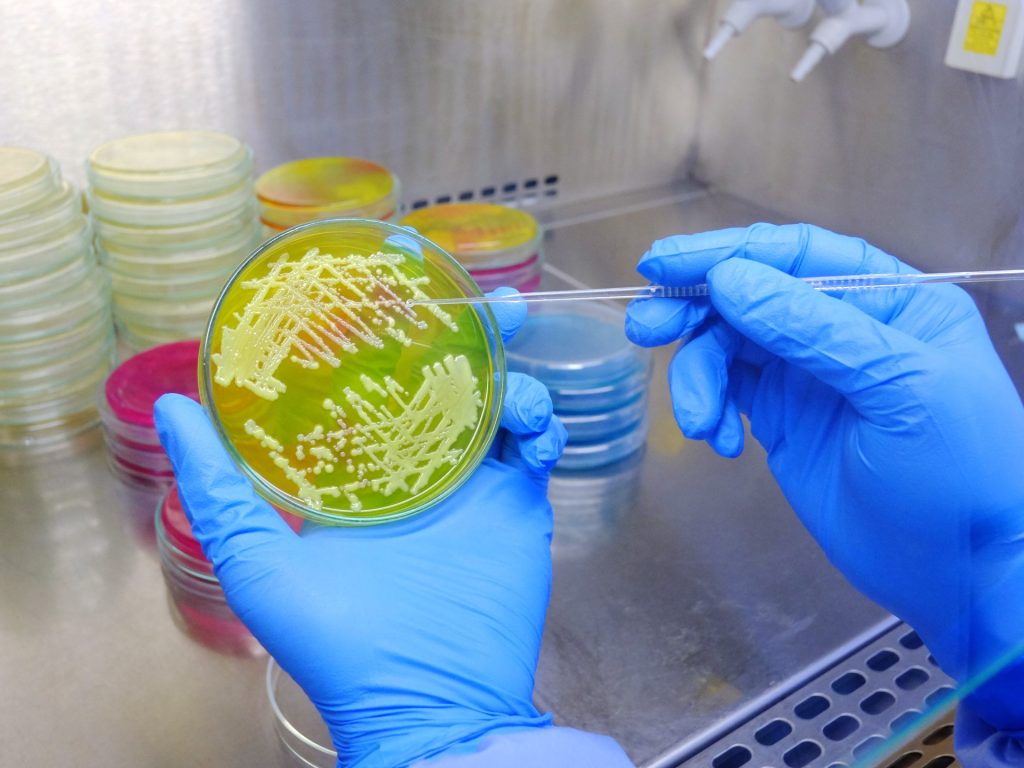

لم تُطرَح في الأسواق منذ أكثر من 30 سنة أي فئة جديدة من المضادات الحيوية، في نقص “صارخ” للابتكارات في مجال أهملته الشركات المُصنّعة للأدوية لأنه لا يدرّ أرباحاً كبيرة.
ومع ذلك، تزداد مقاومة الالتهابات البكتيرية لمضادات الميكروبات، نتيجة الإفراط في وصفها أو سوء استخدامها، مما يجعل عملية الشفاء أكثر تعقيدا، كما هي الحال بالنسبة إلى البكتيريا إيجابية الغرام، المسؤولة خصوصاً عن التهابات المسالك البولية والالتهاب الرئوي والإصابة بالمكورات العنقودية الذهبية، وفق تقرير نشرته وكالة الصحافة الفرنسية.
ويموت شخص كل 25 ثانية بسبب الإصابة ببكتيريا مقاومة، بحسب دراسة نشرتها مجلة “ذي لانسيت” سنة 2022. ومنذ سنوات عدة، أوقف قسم كبير من شركات الأدوية الرئيسية الأبحاث المتمحورة على المضادات الحيوية، والتي تُعدّ طويلة ومعقدة واحتمال فشلها مرتفع، لصالح ابتكار علاجات للأورام أو الأمراض النادرة والتي تدرّ أرباحاً أعلى.
ويشير الأستاذ المتخصص في الاقتصاد لدى جامعة تولوز للاقتصاد، بيار دوبوا، إلى أنّ “الحاجة موجودة، لكن ليس هناك ما يكفي من الاستثمار”.
ومن بين مجموعة صغيرة من شركات التكنولوجيا الحيوية التي تواصل العمل من أجل العثور على مضادات حيوية جديدة “لم ينجح سوى عدد قليل جدا بجمع ما يكفي من الأموال للاستثمار في الأبحاث والابتكار” حسب قول فريديريك بيران، الأمين العام لتحالف “بيم” الذي يرمي إلى تشجيع ابتكار علاجات جديدة للأمراض المقاومة للأدوية.
معضلة
عندما ينجح مختبر في ابتكار مضاد حيوي جديد، لا تكون المبيعات “هائلة” لأنّ المتخصصين في المجال الصحي يريدون “الاحتفاظ بالمضادات الحيوية المبتكرة للحالات الأصعب” أو كما يوضح دوبوا عندما تصبح المضادات الحيوية الشائعة غير فعّالة.
ويهدف هذا الاستخدام المحدود إلى إبطاء تطوّر مقاومة البكتيريا، لكنّ تأثيره الضار يتمثل في الحد من عوائد الاستثمار، مما يشكل “معضلة” للصناعيين الذين يتعين “عليهم ابتكار مضادات حيوية جديدة لكنها في المقابل لا تُستخدم” حسب قول مديرة الشؤون العامة لدى مختبرات “فايزر” الأميركية كاثرين رينو، خلال مناقشة حول العلاج بالمضادات الحيوية في يونيو/حزيران.
ويُعدّ مجال المضادات الحيوية مختلفاً لأنّ العلاجات الحديثة لا تحل محل القديمة التي لا تزال تلبّي معظم الاحتياجات العلاجية.
والحفاظ على هذه المنتجات الجديدة “معقّد لأن الأسعار تنخفض باستمرار” بحسب رينو التي حددت مجموعتها هدفاً يتمثل في إطلاق 2-4 مضادات حيوية جديدة بحلول عام 2030.
بالإضافة إلى ذلك، تُستَهلك المضادات الحيوية لفترة محددة على عكس علاجات الأمراض المزمنة.
صعوبة الربح
يدرك بيران أنّ “هذا القطاع ليس جذاباً جداً” مشيراً إلى أنّ 80% من محفظة المضادات الحيوية قيد الابتكار -في الوقت الراهن- بين أيادي الشركات الصغيرة والمتوسطة.

ومن الصعب جعل المضادات الحيوية الجديدة مربحة، في وقت يتم احتساب أرباح شركات الأدوية على حجم المبيعات، وهو ما يدفع عدداً من الخبراء إلى المطالبة بنموذج دفع آخر لهذه العائلة من الأدوية وحوافز اقتصادية لتشجيع الأبحاث.
وقد أنشأت إنجلترا آلية اشتراك مع الشركات المصنعة للمضادات الحيوية حتى توفّر الأدوية عند الطلب، وهو ما يشبه إلى حد ما نموذج الفيديو حسب الطلب “في أو دي” (VOD).
وميزة ذلك بالنسبة إلى الشركة أن يكون لديها دخل مضمون، أما بالنسبة إلى النظام الصحي فتكمن إيجابيته بالقدرة على التحكم في استخدام المضادات الحيوية لعدم تعزيز ظاهرة المقاومة.
أوروبيا، تجري مناقشات حول إمكانية نقل الحصرية التي من شأنها أن تتيح لشركات الأدوية التي تعمل على ابتكار مضادات حيوية جديدة، وتمديد الاستخدام الحصري لعام واحد على الأدوية الأخرى الموجودة في محفظتها والموجودة أصلاً بالسوق.
ويقول بيران لوكالة الأنباء الفرنسية “كل من يحصل على حصرية يمكنه إما تطبيقها على منتج في محفظته أو بيعها لطرف ثالث”.
ويرى بيار دوبوا أن البديل هو “موافقة الاتحاد الأوروبي على تمويل هذه الأبحاث” معتبراً أنّ الأمر سيكون في كلتا الحالتين “مكلفاً جداً” بالنهاية.